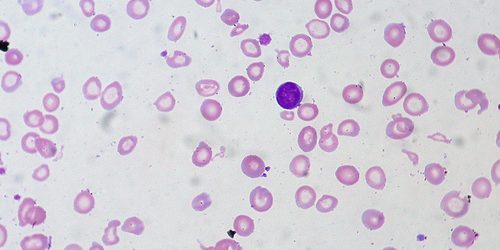

เมื่อพระเจ้าทรงสร้างมนุษย์เราขึ้นมานั้น พระองค์ได้ทรงปกป้อง คุ้มครองและดูแลเราด้วยความรัก ทรงส่งทูตสวรรค์ให้คอยช่วยเหลือเราจากภัยอันตรายต่างๆ และในร่างกายของเรานั้น พระองค์ได้ทรงสร้างให้มีเม็ดเลือดขาวและระบบภูมิคุ้มกัน เพื่อต่อสู้และกำจัดเชื้อโรครวมถึงสิ่งแปลกปลอมต่างๆ เพื่อร่างกายของเราจะปกติ แข็งแรงและไม่เจ็บป่วยค่ะ
วันนี้เราจะมาคุยกันถึงเม็ดเลือดขาว ซึ่งเปรียบเหมือนกับทหารที่คอยปกป้องร่างกาย เม็ดเลือดขาวถูกสร้างจากไขกระดูกและเนื้อเยื่อต่อมน้ำเหลือง เข้าสู่กระแสเลือด และทำหน้าที่วิ่งตรวจตราไปทั่วร่างกาย ในเลือด 1 มิลลิลิตร มีเม็ดเลือดขาวอยู่ประมาณ 5,000-9,000 เซลล์ ในร่างกายของผู้ใหญ่คนหนึ่งมีเลือดไหลเวียนอยู่ประมาณ 5 ลิตร เพราะฉะนั้นเขาจะมีเม็ดเลือดขาวประมาณ 25-45 ล้านเซลล์ เยอะเชียวนะคะ ทหารของเรา เม็ดเลือดขาวยังแบ่งออกเป็น ห้าชนิดซึ่งทำหน้าที่ย่อยๆแตกต่างกันออกไปค่ะ
ขอสรุปภาพการทำงานของเม็ดเลือดขาวง่ายๆ ดังนี้นะคะ เมื่อมีเชื้อโรคหรือสิ่งแปลกปลอมเข้ามายังเนื้อเยื่อของร่างกาย เม็ดเลือดขาวจะรีบรุดออกจากเส้นเลือดไปยังจุดนั้น และจะจับกินเชื้อโรคเข้าไปในร่างกายของมัน โดยส่งน้ำย่อยย่อยเชื้อโรคนั้นจนหมด
เม็ดเลือดขาวของเราทำหน้าที่อย่างสัตย์ซื่อ ดังนั้นถ้าเม็ดเลือดขาวแข็งแรง เราก็แข็งแรง ถ้าเม็ดเลือดขาวอ่อนแอแล้ว เราก็จะเจ็บป่วยติดเชื้อโรคได้ง่ายขึ้น พระคัมภีร์มัทธิว 12:29 ได้พูดถึงความจริงเรื่องนี้ไว้อย่างน่าฟังว่า “ใครจะเข้าไปในเรือนของคนที่มีกำลังมาก และปล้นเอาทรัพย์ของเขาอย่างไรได้ เว้นแต่จะจับคนที่มีกำลังมากนั้นมัดไว้เสียก่อน แล้วจึงปล้นทรัพย์ในเรือนนั้นได้” พระคัมภีร์บอกว่า ถ้าโจรจะเข้าบ้านก็ต้องจับคนมีกำลังมากมัดไว้ก่อน จึงจะปล้นบ้านนั้นได้ เช่นเดียวกันนะคะ บ้านหรือร่างกายของเรามีเม็ดเลือดขาวผู้มีกำลังมากคอยเฝ้าดูแลอยู่ ถ้าสิ่งแปลกปลอมและเชื้อโรคที่เข้ามา สู้ไม่ได้ก็ต้องพ่ายแพ้ไป เราก็ไม่ป่วยค่ะ
ท่านคงอยากให้เม็ดเลือดขาวของท่านแข็งแรง แต่ท่านทราบไหมคะว่า ในแต่ละวัน มีพฤติกรรมหลายๆ อย่างที่ท่านกำลังทำอยู่ ทำให้เม็ดเลือดขาวของท่านถูกมัดหรืออ่อนแอลงไป เช่น การไม่ออกกำลังกาย การมีอารมณ์และความรู้สึกในด้านลบ ไม่ว่าจะเป็น ความเสียใจ ความเครียด ความโกรธแค้น และยังมีอาหารหลายชนิดเมื่อรับประทานเข้าไป จะทำให้เม็ดเลือดขาวอ่อนแอ เช่น ขนมหวาน น้ำหวาน น้ำอัดลม ไอศกรีม หรืออีกนัยหนึ่งก็คือ อาหารชนิดใดก็ตามที่มีน้ำตาลทรายเป็นส่วนประกอบนั่นเองค่ะ จะทำให้เม็ดเลือดขาวอ่อนแอ นอกจากนี้ของทอดต่างๆ อาหารมันๆ ก็ทำให้เม็ดเลือดขาวของเราอ่อนแอด้วย
ท่านคงอยากทราบนะคะว่า มีสิ่งใดบ้างที่ทำให้เม็ดเลือดขาวแข็งแรง ได้แก่ การพักผ่อนให้เพียงพอ การออกกำลังกายสม่ำเสมอ ดื่มน้ำเพียงพอ รักษาร่างกายให้สะอาด แสงแดด อากาศบริสุทธิ์ การรับประทานผักผลไม้ต่างๆ การไม่เครียด ความรู้สึกสงบและขอบคุณพระเจ้า
ก็ขอให้เราทุกคนใส่ใจดูแลเม็ดเลือดขาวของเราให้แข็งแรงนะคะ พบกันใหม่ในรายการครั้งหน้า ขอพระเจ้าทรงอวยพระพร สวัสดีค่ะ